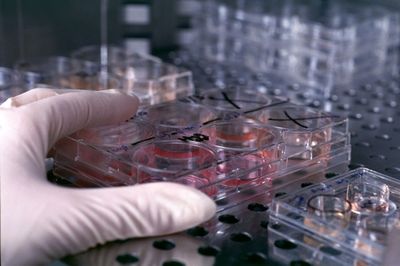

Il 18 aprile scorso, il membro del cda del Cnr, Vito Mocella, eletto dalla comunità scientifica dell’ente, ha inviato un messaggio al personale, per relazionare sull’esito della riunione del consiglio di amministrazione tenutasi il 12 precedente.
Il 18 aprile scorso, il membro del cda del Cnr, Vito Mocella, eletto dalla comunità scientifica dell’ente, ha inviato un messaggio al personale, per relazionare sull’esito della riunione del consiglio di amministrazione tenutasi il 12 precedente.
Tra l’altro, in merito al punto 7 all’ordine del giorno (Varie ed eventuali), il consigliere scriveva testualmente: “Ho sollevato la questione emersa in un articolo di stampa, apparso l'11 Aprile, che riferisce di uno stanziamento del CNR di 11 milioni di euro in due tranche per un centro sulle staminali di Terni diretto da Angelo Vescovi. Sembra che la prima tranche di tale stanziamento sia il frutto di una convenzione, stipulata dalla precedente presidenza, che non è stata né sottomessa né tantomeno approvata dal CdA. Essa pertanto non sarebbe valida e non dovrebbe contribuire, dunque, ad aggravare la già difficile situazione del bilancio dell'Ente”.
Non avendo aggiunto altro e non avendo precisato quale fosse stata la reazione del cda, trattandosi di una comunicazione il cui contenuto, se confermato, potrebbe scatenare una bufera sul Cnr, Il Foglietto ha cercato di saperne di più, avventurandosi in una impresa certamente non facile, dal momento che sul sito dell’ente di piazzale Aldo Moro sembra non esserci traccia delle innumerevoli convenzioni che annualmente il più grosso ente di ricerca del paese sottoscrive.
Innanzitutto, abbiamo scoperto che l’articolo al quale il Mocella faceva riferimento era apparso sul Corriere dell’Umbria; che, tra il Cnr, presieduto da Luigi Nicolais, e la Fondazione Cellule Staminali con sede a Terni, presieduta da Enrico Garaci (già presidente dello stesso Cnr dal 1993 al 1997) esiste una convenzione di durata triennale, con la quale le parti hanno instaurato un “rapporto di collaborazione finalizzato a migliorare la conoscenza delle cellule staminali sane e tumorali e la loro regolazione”; che l’onere a carico del Cnr, contrariamente a quanto scritto dal predetto consigliere, è di 5.111.627 euro e non di 11 milioni; che la convenzione, in effetti, come precisato dallo stesso consigliere non sembra essere stata deliberata dal cda, per cui i dubbi sulla validità della stessa sembrerebbero fondati.
Ma Il Foglietto si è soffermato anche su altri due aspetti della questione, uno formale e l’altro sostanziale.
Il primo riguarda la data di sottoscrizione tra le parti della convenzione, che sembra essere quella di protocollo (1° marzo 2016).
Il secondo attiene alle motivazioni in base alle quali - trattandosi di una iniziativa di notevole rilevanza scientifica e con un considerevole esborso da parte dell’ente - il Cnr, anziché dialogare con un unico interlocutore che, però, non ha l’esclusiva né in Italia né tantomeno in Europa dello specifico argomento, non abbia optato per un bando pubblico per individuare l’organismo qualificato con il quale sviluppare il progetto di ricerca.
Si tratta in definitiva delle stesse motivazioni per le quali il Parlamento, in occasione dell’approvazione della legge di stabilità 2016, ha modificato il cosiddetto “emendamento Sla”, con il quale – se fosse stato approvato – la Fondazione Cellule Staminali avrebbe ottenuto un finanziamento di 3 milioni di euro per effettuare la seconda fase di sperimentazione (su 80 pazienti) di una terapia a base di cellule staminali contro la Sla.
Dopo aspre polemiche, approdate anche sulla stampa [1, 2, 3] l’emendamento venne corretto e il finanziamento verrà ora assegnato con un bando pubblico aperto a tutti i centri che si occupano di cellule staminali.
Appare opportuno, dunque, che il Cnr, dal 20 febbraio 2016 presieduto da Massimo Inguscio, fornisca chiarimenti sulla vicenda: al consigliere Mocella, al Foglietto e, trattandosi di finanziamenti pubblici, anche alla collettività.











